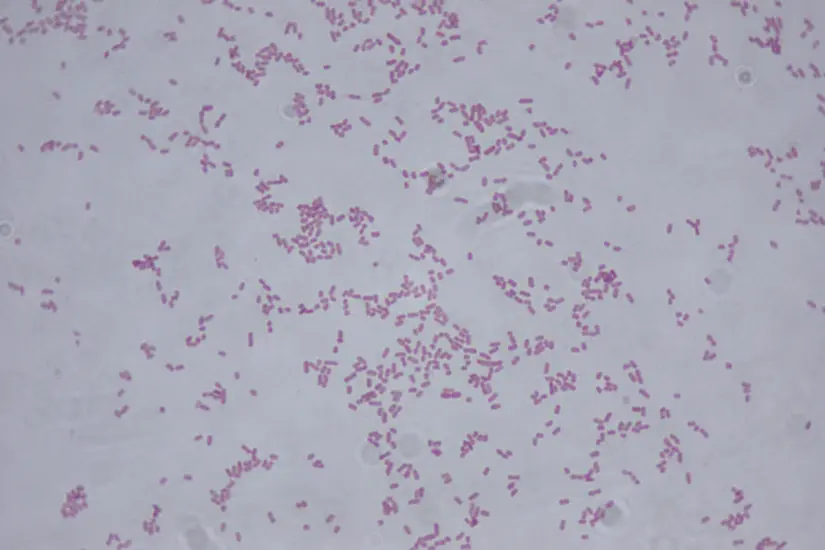

Descartan presencia de la bacteria Klebsiella en Tamaulipas ¿cuáles son sus síntomas?
Aunque esta bacteria es común en nuestro intestino, puede causar enfermedades en ciertas condiciones.

VICTORIA, Tamaulipas.- Las autoridades sanitarias de Tamaulipas se mantienen en alerta ante la detección de la bacteria Klebsiella en algunos estados de la República, realizando una constante revisión de insumos y medicamentos para evitar la entrada de productos contaminados al estado.
El titular de la dependencia estatal, Vicente Joel Hernández Navarro, confirmó que hasta la fecha no se ha detectado la presencia de la bacteria en Tamaulipas, pero se mantienen vigilantes para garantizar la seguridad de la población.
Se ha emitido una alerta sanitaria a nivel federal para verificar que los productos médicos en las unidades hospitalarias no representen un riesgo para la salud, y se trabaja en la prevención del uso excesivo de antibióticos, ya que esto puede generar resistencia y dificultar la eliminación de la bacteria Klebsiella.
Vicente Joel Hernández Navarro, secretario de Salud del Gobierno de Tamaulipas. Foto: SST
Se estima que los nuevos casos de Klebsiella registrados pueden estar relacionados con situaciones de contaminación, generando resistencia que requiere el uso de antibióticos más potentes.
La presencia de esta bacteria puede provocar infecciones graves que pueden llevar a la muerte, por lo que es crucial mantener un control estricto sobre los productos médicos.
Ver nota:
Secretaría de Salud de Tamaulipas confía en que el frío acabe con el dengue
¿Qué es la bacteria Klebsiella?
Las bacterias presentes en nuestro intestino juegan un papel crucial en nuestra salud, sin embargo, cuando se trata de Klebsiella, una bacteria gramnegativa, es importante tener precaución.
Aunque esta bacteria es comensal en nuestro intestino, es importante destacar que puede causar enfermedades en ciertas condiciones.
Klebsiella suele ser más agresiva en personas vulnerables, como:
- Personas con sistemas inmunitarios debilitados.
- Pacientes en cuidados intensivos y hospitales
- Adultos mayores
- Personas con padecimientos pulmonares crónicos
- Recién nacidos, como en el caso del reciente brote identificado en el Estado de México.
Klebsiella observada desde un microscopio. Foto: Wikipedia
Según la Secretaria de Salud federal, la fuente de contaminación en este brote se debió a soluciones de nutrición parenteral contaminadas, las cuales al ser administradas en pacientes bebés, provocaron infecciones severas.
Esta cepa de Klebsiella es resistente a varios grupos de antibióticos, lo que la hace aún más peligrosa y capaz de causar infecciones graves.
Ver nota:
Salud mental y adicciones: alcohol, principal causa de consulta de personas entre 30 y 35 años
¿Cuáles son los síntomas de la Klebsiella?
La Klebsiella es una bacteria que puede causar diversas infecciones en el cuerpo humano, siendo uno de los primeros signos de alarma las infecciones en el tracto urinario, especialmente en pacientes con sondas urinarias.
Sin embargo, también puede provocar infecciones en otros órganos como el sistema nervioso central, heridas quirúrgicas, torrente sanguíneo y neumonía.
En casos más graves, los pacientes pueden desarrollar choque séptico y fallo multiorgánico.
Debido a la gravedad de las consecuencias que puede tener la Klebsiella, es crucial detectarla de manera temprana y aplicar un tratamiento específico. Foto: Freepik
Ver nota:
Salud 'Casa por casa': esto debes saber de la llegada del programa a Tamaulipas